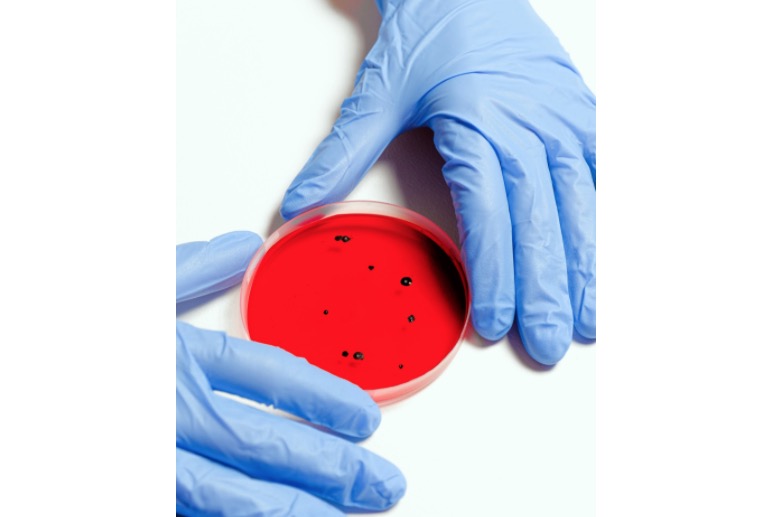
Casos de coronavírus ultrapassam 8 mil e número de mortos não para de subir no Brasil

Manaus/AM - O novo balanço das secretarias estaduais de saúde, divulgado nessa sexta-feira (3), registra 329 mortes e 8.076 brasileiros infectados pelo novo coronavírus até agora.
No Amazonas são 229 pacientes acometidos pela doença e 12 mortos, entre eles, uma criança. O Mato Grosso registrou a primeira morte na manhã de hoje, enquanto a Bahia investiga o quarto óbito.
A maioria dos casos do país continuam em São Paulo, e já são 3.506, com e pouco mais de 115 mortos.

Aviso